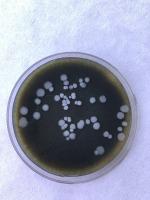

不含动物源性成分的芽孢杆菌幼虫藻类提取物培养基的研制
IF 1.9
Q2 MULTIDISCIPLINARY SCIENCES
引用次数: 0
摘要
类芽孢杆菌(Paenibacillus)幼虫的培养,是美国病原菌的病原体,传统上依赖于含有动物源性营养物质的培养基。为了回应与这些成分相关的伦理和实践问题,我们开发并验证了一种基于藻类提取物的新培养基。该配方包括小球藻作为主要营养来源,并补充了尿酸和l -酪氨酸,以支持孢子在类似蜜蜂幼虫肠道的条件下萌发。该方法包括用于溶解少溶性组分和最小化营养物降解的优化程序。该新培养基与MYPGP及其他常规培养基在支持白颡鱼幼虫孢子萌发和营养生长方面的效果相当。•通过使用微藻营养物质消除了对动物源性成分的需求•支持P.幼虫的强大萌发和菌落发育•提供适合诊断和研究应用的道德和经济高效的培养基本文章由计算机程序翻译,如有差异,请以英文原文为准。
Development of an algae extract-based culture medium for Paenibacillus larvae without animal-derived components
The cultivation of Paenibacillus larvae, the etiological agent of American foulbrood, traditionally relies on media containing animal-derived nutrients. In response to ethical and practical concerns associated with such components, we developed and validated a new culture medium based on an algae extract. The formulation includes Chlorella as the principal nutrient source and is supplemented with uric acid and L-tyrosine to support spore germination under conditions resembling the honeybee larval gut. The method includes optimized procedures for dissolving sparingly soluble components and minimizing nutrient degradation. Performance of the new medium was comparable to that of MYPGP and other conventional media in supporting spore germination and vegetative growth of P. larvae.
• Eliminates the need for animal-derived components through the use of microalgal nutrients
• Supports robust germination and colony development of P. Larvae
• Provides an ethical and cost-efficient medium suitable for diagnostic and research applications
求助全文
通过发布文献求助,成功后即可免费获取论文全文。
去求助
来源期刊

MethodsX
Health Professions-Medical Laboratory Technology
CiteScore
3.60
自引率
5.30%
发文量
314
审稿时长
7 weeks
期刊介绍:
 求助内容:
求助内容: 应助结果提醒方式:
应助结果提醒方式:


